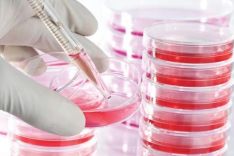

New tiny pacemaker has high implant success rate
19th May 2017
Pacemaker inserted into the heart via a vein in the leg.

19th May 2017
Pacemaker inserted into the heart via a vein in the leg.

18th May 2017
Instead of shock, low energy pulses used.

11th May 2017
Pumps can help some people's heart function return to near normal

4th May 2017
say American researchers.

27th April 2017
says new patient-led research.

17th April 2017
Many hospitals not specialists in treating cardiac arrest survivors.

13th April 2017
says research from America.

10th April 2017
Children with disease in family may get a heart transplant that is not needed, say researchers.

7th April 2017
Magazine looks at cardiomyopathy-related issues, including five steps to mental well-being.
6th April 2017
Cells from people's own thigh muscles cultured in lab.